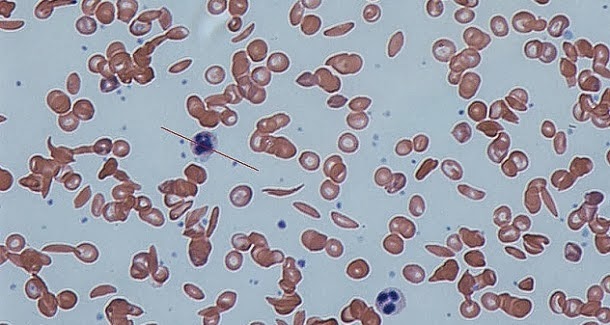

Este distúrbio particular afeta o quinto nervo craniano, um dos mais amplamente difundido no rosto de uma pessoa.
Conhecido nos hospitais como a "doença do suicídio", há dois tipos. O tipo 1 é a aguda, que envolve dor inacreditável disparando através do rosto do sofredor que tem a duração de até dois minutos. Estes ataques podem durar por um período de duas horas de agonia.
O Tipe 2 é menos doloroso, mas ainda é uma das mais difíceis dores que atingem o corpo humano. É constante, em vez de esporádica, com um sentimento de queimar ou choque elétrico doloroso que dura anos.
Analgésicos como a morfina regular não tem efeito e as drogas anti-convulsão muitas vezes perdem a sua eficácia. Vários procedimentos cirúrgicos têm demonstrado sucesso moderado, mas raramente são nada mais do que correções temporárias.
9. Febre Hemorrágica Marburg
Diagnosticada pela primeira vez em 1967, após um surto em uma série de laboratórios em toda a Alemanha e Iugoslávia, a febre hemorrágica de Marburg é uma doença quase idêntica à causada pelo vírus Ébola.
Macacos que tinham sido importados da África foram infectados e disseminaram a doença, enquanto estavam sendo usados para a pesquisa contra a poliomielite. Até ao momento, é extremamente rara, com menos de 1.000 casos notificados até à data, e quase sempre encontrada em África.
Pensasse que o morcego da fruta Africano é a principal fonte de infecção. Os sintomas iniciais são próximos de doenças muito mais comuns, tais como a malária, por isso, o diagnóstico correto pode ser bastante complicado.
Se a infecção for grave o suficiente, sangramento na boca e no recto e problemas neurológicos surgem. Devido à falta de conhecimento científico sobre a febre de Marburg, não há tratamento estabelecido, mas os transplantes de plasma e de proteína no sangue têm mostrado bons resultados.
8. Cancrum Oris
Mais comummente conhecida como noma, cancrum oris é uma infecção gangrenosa que ataca o tecido facial das suas vítimas, geralmente crianças com menos de 6 anos de idade.
Especialmente prevalente em áreas atingidas pela pobreza em África, não só a doença têm uma taxa extremamente alta de mortalidade (80%), mas aqueles que sobrevivem ficam horrivelmente desfigurados.
Afetando cerca de 100.000 crianças a cada ano, os anticorpos no corpo do doente ficam confusos e atacam o tecido mole na bochecha, boca e nariz. Com o progresso rápido da doença, os infectados ficam rapidamente incapazes de falar ou comer normalmente.
A doença só fez breves aparições na Europa e na América do Norte desde a sua erradicação há mais de 100 anos, mais notadamente nos campos de concentração nazistas. Antibióticos podem parar a propagação à primeira vista de uma lesão, mas são muitas vezes inacessíveis ou caros.
7. Capsulite adesiva
Conhecido pelo nome de "ombro congelado", este distúrbio provoca uma dor no ombro do doente tão dolorosa e dura que é praticamente impossível fazer qualquer coisa com o braço. Além disso, pode dificultar o sono, causando uma miríade de outros problemas de saúde, como depressão e ansiedade.
Não há causa conhecida para o ombro congelado, mas diabetes e lesões ou cirurgias na área são considerados factores. Afeta 2 por cento da população em algum momento das suas vidas, tornando-se um dos doenças mais comuns na lista e é extremamente difícil de tratar.
Mesmo com medicação regular e reabilitação física constante, pode levar até um ano para restaurar a mobilidade. Embora tenha havido casos em que desapareceu por conta própria, normalmente leva até dois anos para se resolver.
6. Síndrome de Dor Regional Complexa
Formalmente conhecido como "distrofia simpático-reflexa", é uma doença sistêmica ao longo da vida que se manifesta como dor extrema nos ossos e alterações na pele, bem como sensibilidade inacreditável ao toque.
É uma das doenças mais dolorosas do mundo, classificada acima do parto e amputação no Índice de Dor McGill, um método de avaliação da dor desenvolvido no início de 1970. Inicialmente, acreditava-se ser uma falha sistémica do sistema nervoso simpático, mas atualmente os investigadores acreditam ser desencadeada por trauma, especialmente nas extremidades.
5. Urticária aquagênica
Urticária aquagênica é mais conhecida como alergia à água. Apesar de não ser uma verdadeira alergia, uma vez que a histamina não é realmente liberada pelo organismo, a doença ainda apresenta erupções cutâneas dolorosas onde a água toca na pele.
Geralmente dentro de uma hora após o contato com a água, o doente fica com pequenas pápulas, que são áreas avermelhadas levantadas. É uma doença extremamente rara, com apenas 100 casos notificados em todo o mundo.
Alguns cientistas acreditam que pode haver um componente genético para a doença, como não houve evidência de transmissão de pessoa para pessoa. No entanto, a maioria dos casos ocorrem em famílias separadas, com apenas alguns acontecendo com parentes.
Enquanto alguns casos pode ser muito suave, a maioria são extremamente dolorosos, com os sofredores a recorrer a banhos extremamente curtos ou mesmo a evitar os banhos, de forma a evitar a dor causada pelo contacto.
4. Diarréia de Brainerd
Como você provavelmente pode adivinhar pelo nome, esta doença é uma forma grave, aguda de diarreia descrita pela primeira vez depois de um surto em Brainerd, no Minnesota. A razão exata para a doença é desconhecida, mas pode ser causada pelo consumo de água contaminada ou leite cru.
Os sofredores experimentam entre 10 e 20 episódios de diarréia explosiva e aquosa diariamente. Quase todos os surtos registados ocorreram nos Estados Unidos, embora tenha havido apenas oito. Podem durar meses, até um máximo de um ano, sem descanso para os aflitos, porque é extremamente resistente a qualquer forma de tratamento anti-microbiano.
Fármacos como Imodium têm sido relatados para proporcionar algum alívio, mas apenas em doses muito altas. Como a fonte exata da doença é desconhecida, não há nenhuma medida preventiva conhecida, além de ferver toda a água de poços e evitar leite não pasteurizado.
3. Anemia Falciforme
A anemia falciforme é uma doença genética do sangue em que os glóbulos vermelhos se formam anormalmente, tomando a forma de uma meia-lua ou foice. Além disso, não há células de sangue suficientes parar transportam o oxigénio por todo o corpo.
Aqueles que sofrem também perdem as células do sangue com defeito até 12 vezes mais rápido do que aqueles sem a mutação. Um dos genes responsáveis pela hemoglobina é a causa da doença e parece ser mais prevalente entre aqueles cujos ancestrais viveram em áreas onde a malária era comum.
Os sintomas variam de pessoa para pessoa, mas a fadiga e dor crónica são extremamente comuns e nunca desaparecem. Graças à medicina moderna, não é o assassino que outrora era. Apesar de os transplantes de células-tronco do sangue e da medula mostrarem resultados promissores, ainda não há cura.
2. Adipose dolorosa
Para qualquer pessoa familiarizada com o latim, será óbvio que esta doença em particular tem a ver com a gordura. Também conhecida como "doença de Dercum" em honra ao médico que a descreveu pela primeira vez, os pacientes sofrem com tumores chamados lipomas em todo seu torso.
Quase todos aqueles que têm esta doença são mulheres obesas com idades entre os 35 e os 50. Não existe nenhuma cura ou conhecimento de causa para esta doença. Acredita-se que, talvez, tenha um componente genético, uma vez que parece correr em algumas famílias.
Outros cientistas teorizam que é uma doença auto-imune, com o tecido saudável a ser atacado pelo corpo. Os únicos tratamentos disponíveis para esta condição extremamente dolorosa focam-se num sintoma de cada vez, utilizando medicamentos para a dor e estratégias de perda de peso. A lipoaspiração tem mostrado algum sucesso moderado no tratamento da doença.
1. Maldição de Ondina
Para aqueles não familiarizados com contos populares franceses ou alemães, Ondine era uma ninfa que levou um mortal como seu amante, e jurou que cada uma das suas respirações seria uma prova do seu amor por ela. Depois que ele cometeu adultério, Ondine, ou o seu pai, em algumas versões amaldiçoou o amante para parar de respirar da próxima vez que adormecesse.
Também conhecido como "síndrome de hipoventilação central congênita", quem sofre desta doença tem problemas na função do sistema nervoso autônomo, que regula a respiração. Isso significa que eles tem que se lembrar conscientemente de respirar.
Quando dormem, a maioria estão ligados a ventiladores. Se forem capazes de sobreviver até à idade adulta, as máscaras de dormir que são usadas para tratar a apneia do sono tendem a funcionar bem o suficiente para capacitá-los a viver uma vida relativamente normal.
Acredita-se que a genética desempenha um papel importante como causa da doença, embora tenha aparecido em adultos após passarem por uma grande cirurgia ou trauma.